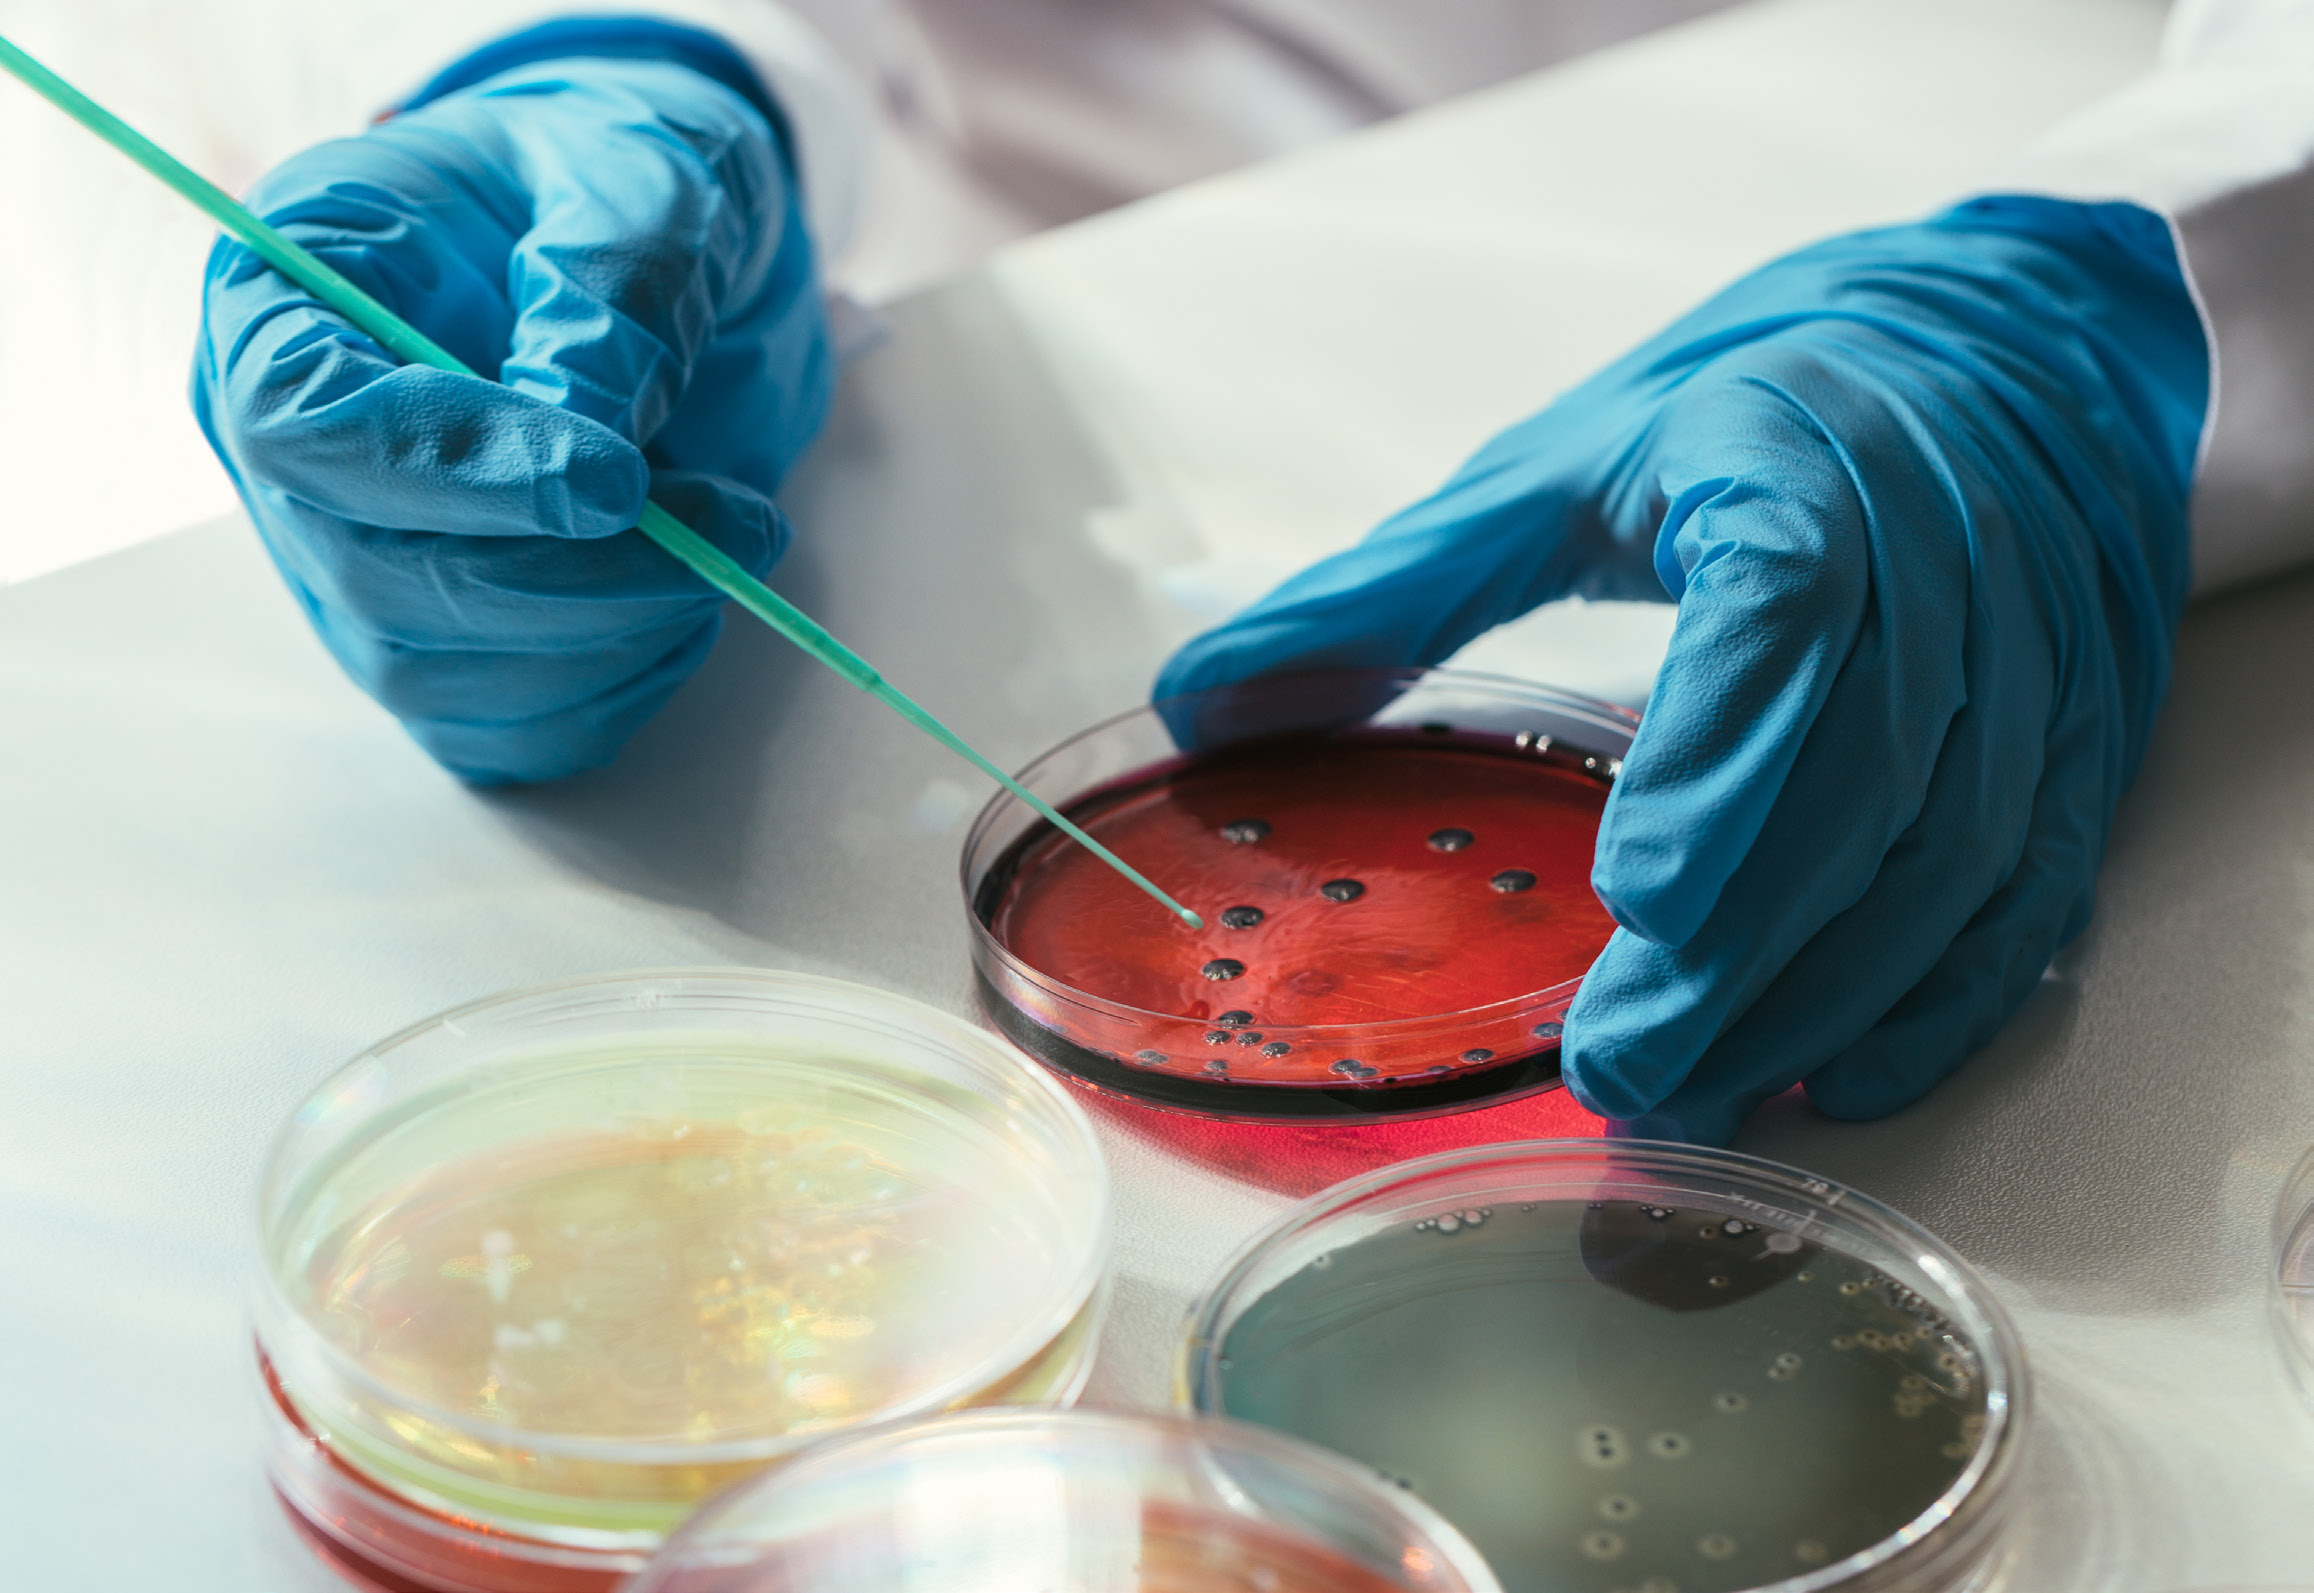
featured graphic

Health Care
Sector Focus: Health Care
The provision of health care is a sensitive political topic at the best of times, but it has become even more so over the last several years. Governments around the world are struggling to cope with the ever-increasing health care burden on public finances in an economic environment where growth is harder to come by. During the 2016 US presidential elections, both candidates attacked the high cost of prescription drugs borne by consumers – and not entirely without justification. Reducing these out-of-pocket costs is now a major strategic objective for the entire health care industry.
The health care industry has always had to balance the need to generate profit against the public good of providing quality medical outcomes for patients at a reasonable cost. In recent years, public pressure on the industry has increased dramatically, as medical inflation combined with stagnant wage growth has seen the cost of health care balloon as a share of household expenditure in many developed markets.
Just why have drug prices gone up so dramatically? We think it is instructive to look at the US market to understand the problem. The US health care market is extremely relevant for what happens in other markets, as it is responsible for a significant portion of global drug spend (42% of the roughly $1 trillion spent per year), as well as total research spending globally (approximately 43% of $165 billion per year).

Source: Bureau of Labour Statistics, American Enterprise Institute
In the US, there is a complex system funding the cost of drugs, combined with an entire drug supply chain that is responsible for getting the drugs from the pharmaceutical company to the ultimate patient. As a rule of thumb, one third of total drug revenue is earned by the supply chain, while the pharmaceutical companies retain two thirds of the total revenues. Pharmaceutical companies get to keep the lion’s share of revenues as they spend a significant amount of resources in developing the drugs that address patient needs. In fact, it is not unusual for these companies to spend billions of dollars and significant amounts of time – often as long as ten years – to fully research a new drug. The drug then undergoes a rigorous series of tests and clinical trials to ensure that it is effective and safe for human usage. Only once all these requirements are met, will the US Food and Drug Administration (FDA) approve the drug.
For the pharmaceutical company, the profits are thus back[1]end loaded: they can only make profit once the drug is approved and being sold to the consumer. Their profits are at risk if other companies can re-engineer those drugs and start selling them without having a commensurate amount of resources invested in research and development. As such, brand name drugs are often patented and protected by patent laws for a period of time. There are few alternatives to these drugs during the period they enjoy patent protection. During this period, these brand-name drugs are often priced very highly, with the view to recoup the costs sunk into developing the drug before generic competition erodes the profitability. It would be fair to say that high input costs and a lack of competition are the main reasons why brand name drugs cost so much. Over recent years, there has been an increased trend of consumers having to absorb “out[1]of-pocket” payments for their prescription drugs. These payments have become material for the consumer, and hence an obvious target for political campaigns to attract voters.
Between the pharmaceutical companies and the supply chain there are many stakeholders that share incentives for consistently higher drug prices. We believe the pharmaceutical business model is heavily reliant on pushing up prices to maintain revenue growth in order to cover the high cost of developing new drugs, while ensuring preferential treatment by the supply chain. In addition, one must have some faith in the pharmaceutical company’s ability to deliver on a pipeline of new drugs, which carries a large degree of forecast risk. We do not think this dynamic is sustainable without some changes, and a regulatory response is already on the cards.
Rebates paid by drug manufacturers for access to patients are under pressure to be reformed. This development is negative for both the supply chain and manufacturers, as the self-serving relationships along the supply chain that endorsed high list prices set by drug manufacturers are being exposed. As a result, lower drug prices for the end consumer are likely to remain in focus. This supports our modest exposure to the pharmaceutical sub-sector, as we believe that pharmaceutical company revenue drivers are structurally challenged over the medium term. We prefer other health care businesses that assist in reducing costs to the overall system.
Since 2016, the highly anticipated release of President Trump's report on US drug prices has been a focal point for the pharmaceutical industry. We interpret this report as negative for the drug supply chain and pharmaceutical companies, as previously “cosy” relationships that enable high list prices are being exposed. The administration has begun to put in place measures to limit or eliminate the incentive for the drug supply chain to support higher prices. Changes to the rebate model could have implications for all participants involved with delivery of drugs to patients, pressuring revenues and profitability.
In our opinion, regulatory intervention will likely see the revenue growth in the pharmaceuticals sub[1]sector capped for the foreseeable future. As such, we prefer exposure to companies responsible for controlling – and reducing – costs for the overall health care system, such as UnitedHealth or Anthem. Ultimately, the drug pricing model will be strongly encouraged to become more transparent, with limits imposed on how much revenue is generated by the various role players in the supply chain. This will take time to legislate, but it leaves us with the impression that manufacturers are not going be able to easily grow revenues without highly differentiated products over the medium term.
